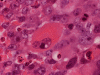

Squash
Squash
Squash
Frozen
Frozen






Synaptophysin
Neurofilament
GFAP
Vimentin
BAF47
| A 4 year-old Girl with a
Rapidly Expanding Mass in the Posterior Fossa. January, 2008, Case 801-1. Home Page |
Hayan Dayoub, M.D.1, Kar-Ming Fung, M.D., Ph.D.2 Last update: February 28 1, 2008.
1Department of Neurosurgery and 2Department of Pathology, University of Oklahoma Health Sciences Center, Oklahoma City, Oklahoma
Clinical information: The patient was a 4 year-old girl. She was admitted to the emergency room about 6 months ago because of trauma. An MRI performed at that time did not demonstrate any lesion in the brain. She presented recently with headache and ataxia and was brought to her physician again. An MRI revealed a large eccentric mass in the posterior fossa that was enhancing. The mass was excised and yielded the following representative images.
 |
 |
 |
 |
 |
 |
 |
|
A. Squash |
B. Squash |
C. Squash |
D. Frozen |
E. Frozen |
F. | G. |
|
 |
 |
 |
 |
 |
|
| H. |
I. Synaptophysin |
J. Neurofilament |
K. GFAP |
L. Vimentin |
M. BAF47 |
Pathology of the Case:
The volume of tissue received for examination amount to an aggregate of 4.0 x 2.0 x 1.5 cm in combined size. Grossly, the tissue is soft and has a creamy color with hemorrhage. The intraoperative cytologic preparation demonstrate a neoplasm composed with small to medium sized blue cells that smear out rather homgeneously and evenly. If you pay attention, there are some larger cells with a substantial amount of cytoplasm even at low magnification (Panel A). On high magnification, the nuclei are rather uniformly large, with high grade of pleomorphism, and almost all cells contain a distinct nucleoli. Apoptotic bodies and mitoses are frequent (Panel B). There are also large cells with prominent nucleoli and substantial amount of eosinophilic cytoplasm. These cells are suggestive of rhabdoid cells but none of them have the distinct inclusion body like cytoplasmic eosinophilic body of the rhabodid cells in atypical teratoid rhabodid tumor (Panel C). In the frozen section, both small to medium sized cells and cells with large nuclei with large, prominent, and eosinophilic nucleoli (Panel D and E). In the permanent sections, there is extensive necrosis (Panel F). The histology is in general agreement with that of frozen section except that the tumor cells appear to have more cytoplasm and more plemorphic, large nuclei with prominent nucleoli in comparison to the frozen section (Panel G). Large cells with substantial volume of cytoplasm, large, bizarre nucleoli and prominent, eosinophilic nucleoli are also noted (Panel H). There is a generalized degree of high grade pleomorphism. Results of immunohistochemistry are as follow:
Comment: This is an interesting case. Histologically, the overall morphology is consistent with a medulloblastoma with high grade of pleomorphism. Therefore, a diagnosis of large cell (anaplastic) medulloblastoma is the most likely diagnosis. The problem is the large cells with substantial amount of cytoplasm and large bizarre, eccentric nuclei with large nucleoli. These features raise the possibility of an atypical teratoid rhabdoid tumor (ATRT). These cells, if you observe carefully, lack the cytoplasmic, eosinophilic, inclusion body typical for rhabdoid cells. Nuclear wrapping is not readily seen. In fact, we did not find unmistakable nuclear wrapping until we looked at the immunohistochemistry for neurofilament. There are three immunohistochemical features in this case that are against a diagnosis of ATRT. First, vimentin is typically positive in most, if not all, tumor cells particularly those cells with rhabdoid changes. Second, most ATRT are positive for EMA. Third, the most powerful proof is the positive immunoreactivity of BAF47 which would be negative in ATRT. The negative result for desmin is helpful in ruling out the possibility of a rhabdomyosarcoma.
| DIAGNOSIS: Large Cell/Anaplastic Medulloblastoma, WHO grade IV. |
Discussion:
General Information:
Medulloblastoma is the most common malignant brain tumor of the childhood with its peak incidence between 5-10 years of age. A small proportion of them are seen in young adults. As per the diagnostic criteria of the World Health Organization (WHO)1, medulloblastomas occur exclusively within the posterior fossa. Most typically, they occur as an enhancing solid mass located at the midline of the cerebellum. Biologically, medulloblastoma have phenotypic features of the very early developmental stages of the central nervous system (CNS). Histologically, they are closely reminiscent of the ventricular zone during development of the CNS. Typically, there is a significant number of mitotic figures and apoptotic cells in medulloblastomas, a feature that can be seen in the developing CNS.. As per the WHO classification, tumors with similar histology that occurs outside the posterior fossa are termed primitive neuroectodermal tumor (PNET). Although histologically similar, there are differences between medulloblastomas and PNETs other than their locations. Due to its strategic location, symptoms and signs due to hydrocephalus and disturbance of cerebellar functions are the most common clinical manifestations. Dissemination through the spinal cord is a common event.
The classic or conventional type of medulloblastoma has a 5-year survival rate of 60-80%. Several variants of medulloblastoma exists. Desmoplastic medulloblastoma and medulloblastoblastoma with advanced neuronal development (also known as medulloblastoma with extensive nodularity) behave less aggressively. Large cell (anaplastic) medulloblastomas have less favorable prognosis. In the pass, melanotic medulloblastoma and medullomyoblastoma are now considered variants of medulloblastomas in the 2007 WHO classification.
Pathology:Medulloblastomas usually have a relatively well defined demarcation from the non-neoplastic brain tissue. Extension to the leptomeningeal surface which lead to "sugar coating" appearance in MRI scan and on gross examination is rather characteristic. This feature, however, is not always present. Cut surfaces of the tumor is usually soft and pale. Necrosis can be present but is usually not extensive. Unfortunately, specimens submitted to for intra-operative frozen section consultation is almost always too small to appreciate these features. Instead, the biopsy material carry a rather characteristic thick mucus like paste.
Histologically, our discussion will be limited to the conventional or classic type of medulloblastoma and large cell and anaplastic medulloblastoma. The conventional or classic type [Click here to see images of a classic medulloblastoma] is essentially a blue cell tumor with extremely high nuclear to cytoplasmic ratio. A solid sheet like growth without specific pattern formation is common. Homer Weight rosette can be seen but they are not frequent features. Fine threads of cytoplasm, also known as neuropils, are rather typical. On histologic sections, the nuclei are rather homogeneous in size. Morphologically, they resemble raisin or crumbling carrots. Mitotic figures are common. Cells with pyknotic nucleoli and apoptotic cells are usually present. necrosis may be seen and usually occur as small spotty areas. The histopathologic features on frozen sections are similar. Similar to other small blue cell tumors, however, preservation of nuclear details is usually suboptimal. Intraoperative cytologic preparations is the best remedy and would provide excellent cytologic and nuclear details. It should be noted that even though the nuclear appear homogeneous in size on fixed sections, a good range of variation in nuclear size with the smaller nuclei about one third the size of the largerest nuclei can be seen. The larger nuclei are often bilobed. The chromatin, regardless of the nuclear size, typically give a coarse, "dirty", hyperchromatic appearance. A large, prominent nuclei is not a classic features and when this particular feature is present, a diagnosis other than a classic medulloblastoma should be entertained. In well done cytologic preparation, a thin rim of cytoplasm can be seen in a small proportion of the nuclei. The majority of the nuclei, however, would exist as naked nuclei.
Large cell and anaplastic medulloblastomas are recognized as different variants in the new WHO classficiation 1. They share many basic features with medulloblastoma 2, 3. The most notable differences are large cell size, increased variation of nuclear size, prominent and even eosinophilic nucleoli, increased mitotic figures and number of pyknotic or apoptotic cells, and extensive, geographic areas of necrosis. In the experience of the authors, most of the tumor cells in large cell and anaplastic medulloblastomas have high nuclear to cytoplasmic ratio in a manner similar to that of the classic variant. As per the new WHO classification, large cell medulloblastomas are composed mainly of large cells with more cytoplasm than the classic variant or the anaplastic variant. In the experience of the authors, this distinction is not always possible. The case being illustrated here includes some large cells with substantial amount of cytoplasm and but these cells only represent a portion of the tumor cell population. In general, anaplastic and large cell medulloblastomas have less favorable prognosis than the classic variant of medulloblastoma. However anaplastic changes are uncommon and does not affect the prognosis in adult cases as per one study 4.
Immunohistochemistry, both classic, anaplastic, and large cell variants are similar. Immunoreactivity for synaptophysin can be demonstrated in most of the tumors. A small tumor that is negative for synaptophysin should raise a serious questions about the diagnosis of medulloblastoma. Expression of other markers such as neurofilament proteins, markers of photoreceptors, and glial fibrillary acidic protein (GFAP) can be seen. In contrast to glial tumors, mutation of p53 is quite uncommon. Isochromosome 17 is the most consistent genetic changes but it should not be used as a diagnostic tool. C-MYC gene amplification is also a common genetic alteration and has been shown to be related to anaplasia . Although studies have linked c-myc and N-myc gene overexpression with anaplasia and a poorer prognosis, this still appears somewhat controversial 5, 6, 7. Based on a study with gene expression profile 8, medulloblastoma with better prognosis are associated with expression of genes that influence cerebellar differentiation (incluing the TRKC and sodium channel gene) and extracellular matrix genes (including elastin and collagen type V gene). Expression of cell proliferation and gene metabolism (including MYBL2 and LDH) are associated with bad prognosis. Epithelial membrane antigen (EMA) is usually negative in medulloblastoma. The possibility of an atypical teratoid rhabdoid tumor (ATRT) should be considered when a medulloblastoma-like tumor with positive immunoreactivity for EMA must be considered. Expression of cytokeratin can be present in a spotty manner. Extensive expression of cytokeratin should raise the possibility of a metastatic carcinoma.
Differential Diagnosis:
With the age and location considered, the list of differential diagnoses is not terribly long. The more common ones are discussed.
First, it is important to know about the history of the patient. Metastatic carcinoma with small cell features, particularly small cell carcinoma or large cell carcinoma are quite unusual in the pediatric age group. The pathologist, however, should make sure that there is no prior history of sarcoma or other malignant tumor. This is typically not a difficult task.
ATRT shares many features with large cell (anaplastic) medulloblastomas. First, most of them occur in infants and children but ATRT are a lot more common in children under three years of age. Both tumor are highly malignant. In fact, the rapid growth as documented in this case lead to the consideration of ATRT before surgery. Second, both entities are featured by large cells with large nuclei and prominent nucleoli. During frozen sections, it may be a difficult task to distinguish these tumors. The rhabdoid cells in ATRT my not be very characteristics and a medulloblastoma like component is not uncommon in ATRT. Also, the rhabdoid cells may not be that numerous and the pathologist has to search for them. The intraoperative cytologic preparations provide excellent cytologic and nuclear details. In general, cells of large cell medulloblastoma do not have the typical eccentric nuclei and cytoplasmic inclusion like bodies in comparison to ATRT. In addition, although the nucleoli are large, they are not as prominent and eosinophilic as in ATRT. Third, cells of ATRT tend to be more intact and large cell (anaplastic) medulloblastomas tend to have predominantly naked nuclei. Distinction of the two entities on permanent sections is usually not a major problem. It should be noted that ATRT are polyphenotypic. However, they are usually positive for EMA which is typically negative in medulloblastoma and its variants. The greatest help would be immunohistochemistry for BAF-47. This antibody recognizes the protein coded by INI1 gene which is the critical gene on chromoome 22q11.2. This gene is expressed in normal tissue as well as neoplastic tissue except in the tissue where this gene is deleted and ATRT is the prototype 9. In some cases of ATRT, the staining can be patchy. The genetic deletion can be confirmed by fluorescent in situ hybridization. In a minority number of cases, no chromosome 22q11.2 deletion is demonstrated. The gene can be sequence in order to search for mutation of the INI1 gene.
The other two important differential diagnoses that must be seriously considered in this location are anaplastic ependymomas and choroid plexus carcinoma. It should be noted that ependymal tumors are often, but not always, positive for EMA. The high grade tumor tends to have less immunoreactivity than the low grade tumors but this features does not really help. On the contrary, careful search for histologic architecture of ependymal tumors is important.
Choroid plexus tumor are positive for transretinin but unfortunately the immunohistochemistry is not very consistent and the results are often difficult to be interpreted. In addition, they are positive for GFAP which add confusion. It should be noted that choroid plexus carcinoma are rarely seen in infants older than three year-old. Second, areas with classic features of adenocarcinoma are usually present and in a respectable volume. In contrast, carcinoma-like areas can be seen in ATRT but they are not common and typically not in a respectable amount. Last, immunohistochemistry of BAF-47 and FISH for deletion of chromosome 22q11.2 are always helpful.
Metastatic small blue cell tumors such as Ewing's sarcoma can be one possibility. Knowing the relevant clinical information would be helpful.
Lymphoma, metastatic small cell carcinoma, and metastatic large cell neuroendocrine carcinomas are also in the list of differential diagnosis if the patient is an adult. Clinical information would be particularly helpful. First, these tumors are quite uncommon in children and young adults. Second, it is not uncommon that these tumors present as multiple lesions. Distinguishing these tumors in intraoperative consultation may be tricky but immunohistochemistry should clear up the confusion without much difficulty.
Reference:
Louis DN, Ohgaki H, Wiestler, Cavenee WK. WHO Classification of Tumours of the Central Nervous System. World Health Organization, 2007.
Eberhart CG, Kepner JL, Goldthwaite PT, Kun LE, Duffner PK, Friedman HS, Strother DR, Burger PC. Histopathologic grading of medulloblastomas: a Pediatric Oncology Group study. Cancer. 2002 94:552-60. 2
Perry A. Medulloblastomas with favorable versus unfavorable histology: how many small blue cell tumor types are there in the brain? Adv Anat Pathol. 2002 Nov;9(6):345-50.
Giordana MT, D'Agostino C, Pollo B, Silvani A, Ferracini R, Paiolo A, Ghiglione P, Chio A. Anaplasia is rare and does not influence prognosis in adult medulloblastoma. J Neuropathol Exp Neurol. 2005 64:869-74.
Stearns D, Chaudhry A, Abel TW, Burger PC, Dang CV, Eberhart CG. c-myc overexpression causes anaplasia in medulloblastoma. Cancer Res. 2006 66:673-81.
Min HS, Lee YJ, Park K, Cho BK, Park SH. Medulloblastoma: histopathologic and molecular markers of anaplasia and biologic behavior. Acta Neuropathol (Berl). 2006 112:13-20.
Eberhart CG, Kratz JE, Schuster A, Goldthwaite P, Cohen KJ, Perlman EJ, Burger PC. Comparative genomic hybridization detects an increased number of chromosomal alterations in large cell/anaplastic medulloblastomas. Brain Pathol. 2002 12:36-44.
Pomeroy SL, Tamayo P, Gaasenbeek M et al. Prediction of central nervous system embryonal tumour outcome based on gene expression. Nature. 2002 415:436-42.
Sigauke E, Rakheja D, Maddox DL, Hladik CL, White CL, Timmons CF, Raisanen J. Absence of expression of SMARCB1/INI1 in malignant rhabdoid tumors of the central nervous system, kidneys and soft tissue: an immunohistochemical study with implications for diagnosis. Mod Pathol. 2006 19:717-25.